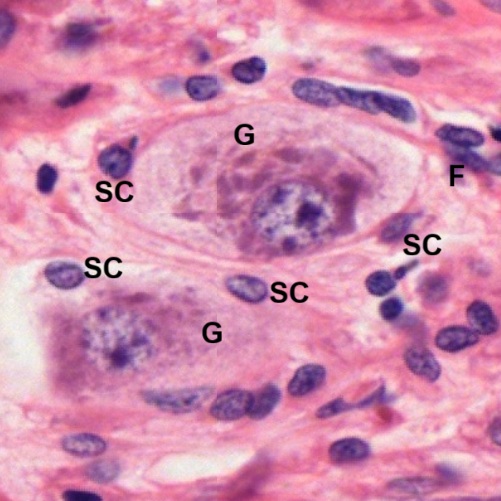
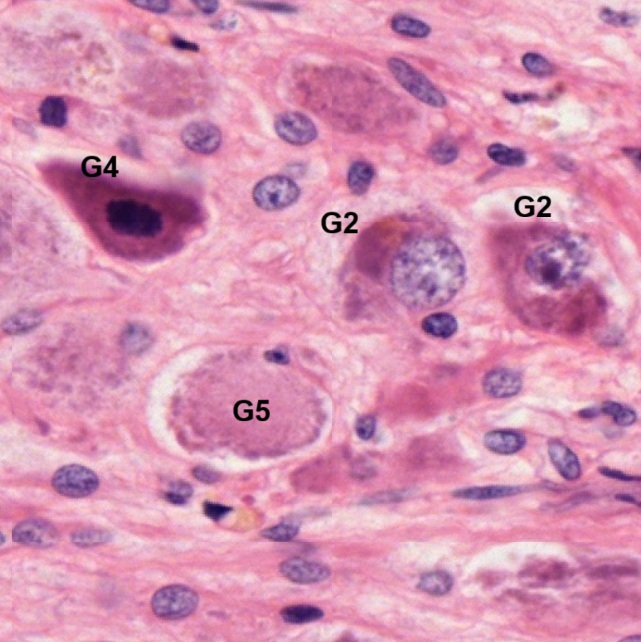
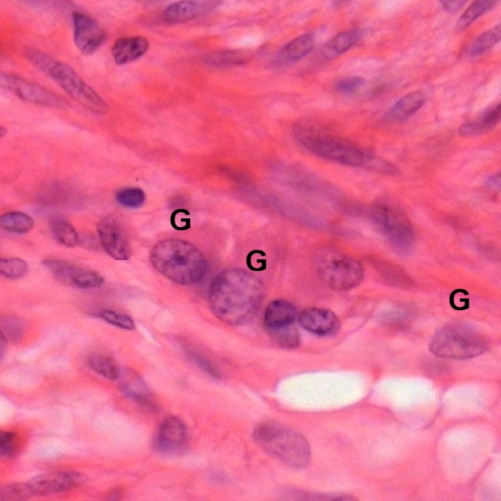
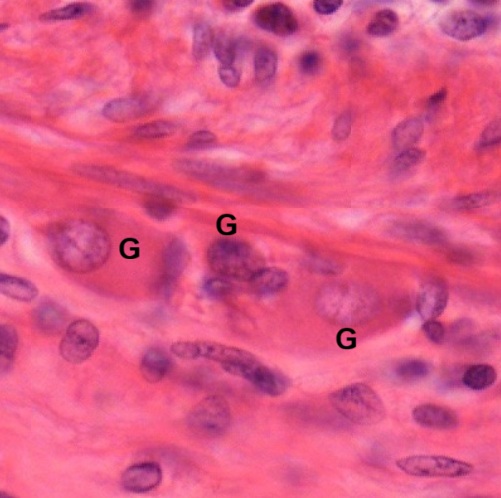

Like the other three types of basic tissues in human body, the nervous tissue is composed of cells, namely neurons. Each neuron owns one elongated process, namely axon, and many short processes, namely dendrites. Depending on the number of dendrites possessed, in human body, a neuron can be pseudounipolar with an axon extending from then cell body then splitting into two branches, bipolar with an axon and one dendrite, or multipolar with an axon and several dendrites. The size of a neuron usually measures its cell body without process, namely neuronal soma or perikaryon, and varies from 4 to more than 100 microns. The axon can extend to everywhere in the body. Its terminals eventually form terminal boutons or synaptic boutons contacting on target neurons or muscle fibers. The aggregations of neurons with outnumbered neuroglial cells form brain, spinal cord, and ganglia. Brain and spinal cord are continuous organs located within cranial cavity and vertebral column, comprising the central nervous system. The extended axons are bundled into nerves with names indicating their location. Nerves and ganglia are outside the cranial cavity and vertebral column to organize into the peripheral nervous system.
Neuron
Smear preparation of mammalian spinal cord stained by methylene blue (Fig. 7-1) is a good way to observe characteristic morphology of neurons. A large neuron is found to have a soma (Sm) of more than 100 um in diameter (Fig. 7-2). Inside the soma, a centrally located nucleus can be seen although it becomes ambiguous due to covering of stained organelles. This is a multipolar neuron with one axon (A) and many dendrites (D). Small cells are also seen around the large neuron (Fig. 7-3). They are small neurons (N1, N2, N3) or neuroglial cells (Ng). The small neurons (N2, N3) have a diameter smaller than 7 um. Due to preparation, many small neurons are not seen to have axon and dendrites, but occasionally small neuron is found to have a long axon with short dendrites (Fig. 7-4).
Structures of various neurons can be observed under the light microscope in sections of spinal cord, cerebrum, and cerebellum stained by HE (Figs. 7-5 ~ 7-7). In the ventral horn of spinal cord (Fig. 5), many motor neurons with other small neurons and neuroglial cells are seen. Five motor neurons are located (Fig. 7-6). Three of them have clear cut centrally located nuclei with condensed nucleoli (N1, N4, N5). One motor neuron contains a nucleus covered by cytoplasmic organelles. Although none of them show long axon, a clear zone in soma is found at one end opposite to dendrites of 4 motor neurons. These are axon hillocks (A), where the axons extend from. Pick one motor neuron (N5) to focus (Fig. 7-7), it is found that the nucleus (N) has a clear cut nuclear envelope and contains condensed nucleolus and dispersed chromatin. There are many basophilic clumps filled inside the soma except the portion of axon hillock (A). These basophilic clumps are aggregates of rough endoplasmic reticulum, known as Nissl bodies, as stated previously in the chapter of CELL. Certain organelles such as cytoskeletons and mitochondria may also be found in dendrites (D).
In a section of the cerebral cortex stained by HE, cortical neurons are arranged in layers from cortical surface (CS) downward (Fig. 7-8). The predominant neurons in the cortex (Fig. 7-9) are pyramidal neurons (P). There are also granular neurons (G) scattered in the cortex. Pyramidal neurons have their dendrites extending from various angles with a top one (D) extending toward the cortical surface. Small neuroglial cells (Ng) are also seen. At higher magnification (Fig. 7-10), two pyramidal neurons are found to have their axons (A) extending toward the direction opposite to dendrites (D).
In the cerebellar cortex, neurons are also arranged in layers from cortical surface (CS) downward (Fig. 7-11). The largest neurons in the cerebellar cortex are Purkinje cells (P). They form a single-cell layer in the cortex. Small neurons (N) can be seen around them with neuroglial cells (Ng) mostly underneath the Purkinje cells (Figs. 7-12 and 7-13). The Purkinje cells (P) have bifurcated dendrites (D) extending toward the cortical surface. In the layer underneath the Purkinje cells, it is filled with numerous neuroglial cells (Ng). Among them, few small neurons (N) can be seen (Fig. 7-14).
Neurons can also be found in the peripheral nervous system. They aggregate into ganglia to form spinal ganglia, sympathetic ganglia and parasympathetic ganglia.
Spinal Ganglia
There are 31 pairs of spinal ganglia, also known as dorsal root ganglia, . Each of them is located on the dorsal root of each spinal nerve lateral to the spinal cord. The pseudounipolar neurons in the spinal ganglion have a single process extending from the cell body and then splitting into two branches. One goes to the periphery perceiving sensory information, and the other goes to the spinal cord to conduct sensation.
In a section of a spinal ganglion stained by HE (Fig. 7-15), a capsule (arrow) with attached adipose tissue (A) is seen to envelope the entire ganglion. Both ends of the ganglion are connected with nerve bundles of the dorsal roots (Dr). The capsule (C) is composed of collagenous fibers (Fig. 7-16). It contains blood vessels (BV) and adipose tissue (A). Both collagenous fibers (F) and nerve bundles (N) are found to invaginate into the ganglion and diffuse among ganglion cells (G). No matter if the ganglion cell is large (Fig. 7-17) or small (Fig. 7-18), each ganglion cell is surrounded by a layer of capsule cells (black arrows) followed by a layer of fibroblasts (white arrows). The capsule cells are also known as satellite cells. They are glial cells providing nutrients, structural support, and acting as a protective cushion for ganglion cells. Each ganglion cell has a centrally located nucleus with a condensed nucleolus. Aggregates of basophilic clumps are seen to fill in the cytoplasm. They are Nissl bodies as mentioned above in the motor neurons of spinal cord (Fig. 7-7). An area of cytoplasm without Nissl bodies is the axon hillock (AH).
The axon hillock (AH) is the site where the axon extends from the soma of a neuron. Through observation of the following micrographs (Figs. 7-19, 7-20, and 7-21) taken from the section of the spinal ganglion, three-dimensional image of a pseudounipolar neuron can be reconstructed in mind: a single neurite extends from axon hillock (Fig. 7-19); then the neurite starts to bifurcate (Fig. 7-20); finally, one axon and one dendrite continue to extend towards the opposite directions (Fig. 7-21).
A clump of capsule cells (C) is observed (Fig. 7-22). It is surrounded by collagenous fibers (CF) with fibroblasts (F). This appearance is due to sectioning through the layer of capsule cells occasionally. Recent research indicates that capsule cells, or satellite cells, may play roles in pain signaling, response to nerve injury, and potential stem cell-like properties.
Sympathetic Ganglia
Sympathetic ganglia are clusters of ganglion cells located just outside the spinal cord in two long chains, known as the sympathetic trunks. Ganglia are grouped into cervical, thoracic, lumbar, and sacral regions. There are 21 or 23 pairs of them, along with a single unpaired ganglion at the very end called the ganglion impar. They are composed of multipolar neurons surrounded by a layer of satellite cells.
In section of a sympathetic ganglion stained by HE (Fig. 7-23), sympathetic nerve fibers (SN) are seen to pass through the entire sympathetic ganglion (SG) which is encapsulated by connective tissue (arrow). This fibrous capsule (FC) is made up of collagenous fibers (Figs. 7-24 and 7-25). Adipose tissue (A) is also found to be attached to the fibrous capsule.
It is found that sympathetic ganglion cells are smaller than spinal ganglion cells (Figs. 7-17, 7-27, 7-27, 7-28). They are also surrounded by a layer of satellite cells (SC) followed by a fibrous layer (arrow) with fibroblasts (F). Similar to spinal ganglion cells, sympathetic ganglion cells (G) have a big round nucleus with a condensed nucleolus and contain aggregates of basophilic clumps in the cytoplasm. These clumps apparently are bigger than those seen in the spinal ganglion cells (Fig. 7-17). They are Nissl bodies and possible other organelles. Some sympathetic ganglion cells also contain lipofuscin granules (Lf) inside the cytoplasm. Research studies indicate that the appearance of lipofuscin granules could be related to the ageing process. Certain axonal processes (Ax) extending from ganglion cells seem to join into adjacent nerve bundles (N).
Through observation, it is found that ganglion cells present different cellular appearance based on morphological criteria (Figs. 7-29, 7-30, 7-31, and 7-32). Most ganglion cells (G1) have basophilic structures surrounding the big round nucleus in the central area and leave the cytoplasmic brim pale stained with less basophilic structures (Figs. 7-29, 7-30, 7-31). Some of them (G2) have a huge basophilic structure closely covering or connecting to the nucleus. Others (G3) have many bigger basophilic structures appearing inside the cytoplasm. The cytoplasm becomes basophilic with appearance of condensed nucleus and vacuoles (Fig. 7-30). Few ganglion cells (G4) have shrunk cell body with condensed nucleus and basophilic cytoplasm (Figs. 7-31 and 7-32). These ganglion cells may be in a process of cell death. One ganglion cell (G5) is observed to have basophilic structures arranged in a circle at the cytoplasmic brim (Fig. 7-32). Lipofuscin granules are found in G2 of Fig. 7-29, G3 of Fig. 7-30, G1 of Fig. 7-31, and G2 of Fig. 7-32.
More examples of ganglion cells with different appearance are shown (Figs. 7-33, 7-34, and 7-35). G1 = ganglion cells which have basophilic structures surrounding the big round nucleus in the central area and pale stained cytoplasmic brim pale with less basophilic structures. G2 = ganglion cells which have a huge basophilic structure closely covering or connecting to the nucleus. G3 = ganglion cells which have many bigger basophilic structures appearing inside the basophilic cytoplasm with appearance of condensed nucleus and vacuoles. G4 = ganglion cells which have shrunk cell body with condensed nucleus and basophilic cytoplasm. G5 = ganglion cells which have basophilic structures arranged in a circle at the cytoplasmic brim.
In a sympathetic ganglion treated with silver impregnation (Figs. 7-36, 7-37, 38, and 39), ganglion cells are found to be multipolar with one axon and many dendrites, Black fibers shown in the background are reticular fibers. Neurite processes are stained brown.
Parasympathetic Ganglion
It is a group of neurons located near or within the organs they innervate. In the head and neck there are four larger paired ganglia, such as ciliary, pterygopalatine, otic, and submandibular ganglia. They receive fibers from preganglionic neurons in the brain and spinal cord, then send out fibers and synapse with postganglionic neurons of the ganglion located within target organs like the heart, lungs, and digestive system.
The main parasympathetic ganglia in the intestine are the tiny, interconnected ganglia of the myenteric plexus, also known as Auerbach’s plexus (Figs. 7-40 and 7-41), located between the muscle layers, and the ganglia of the submucosal plexus, also known as Meissner’s plexus (Figs. 7-42 and 7-43). Ganglion cells (G) in both plexuses are the same size, but myenteric plexus is bigger than submucosal plexus.
Among neuronal processes, long axons end up making synaptic contacts on other neuronal bodies or dendrites in the central nervous system. In the peripheral nervous system, axons from motor neurons of spinal cord make synaptic contacts on muscle fibers to form neuromuscular junctions, which can be visualized as motor end plates at light microscopic level. In the path to synaptic contacts, these peripheral axons are enveloped by Schwann cells. Small axons, such as autonomic fibers or small fibers conducting pain sensation, are simply enveloped by the cytoplasm of Schwann cells. These nerve fibers are known as unmyelinated or non-myelinated fibers. If one axon is wrapped by concentric layers of the plasma membrane of Schwann cell forming a myelin sheath, then, this nerve fiber is known as myelinated fiber. In the central nervous system, myelination is similar to that in the peripheral nervous system except that the myelin sheaths are formed by neuroglial cells called oligodendrocytes.
Myelinated Nerve Fibers
Each nerve with known name in anatomy is encapsulated by fibrous connective tissue with adipose tissue. The fibrous connective tissue invaginate into the bundle to cover on individual nerve fasciculus (F). Then, the fibrous connective tissue enters the fasciculus to envelope individual nerve fibers. This encapsulation of fibrous connective tissue is best seen in cross sections of nerve bundles stained by HE (Fig. 7-44). The fibrous capsule of the entire nerve bundle is known as epineurium (Ep). The fibrous connective tissue covering individual nerve fasciculus (F) is known as perineurium (Pe). Inside each fasciculus (Fig. 7-45) nearing the perineurium (Pe), the fibrous connective tissue, known as endoneurium (En) is found to envelope individual nerve fibers (N). Empty spaces are seen between endoneurium and nerve fibers due to tissue shrinkage during preparation. In different cross section (Fig. 7-46), theses artificial spaces are found to be fewer. The endoneurium (En) envelopes nerve fibers (N) closely. Observation at high magnification (Fig. 47) reveals that there is lifebelt-like structure surrounding each nerve fiber (N). It is myeline sheath (MS) formed by Schwann cell (SC). Endoneurium (En) is made of fibrous connective tissue stained red.
In a longitudinal section of two nerve bundles stained by HE (Fig. 7-48), it can be seen that each nerve bundle (N) is encapsulated by epineurium (Ep) with adipose tissue (A) attached. Inside the nerve bundle, perineurium (Pe) separates it into two neve fasciculi (F). At high magnification, an axon (A) is seen to be surrounded by empty vacuoles or patched structures. These vacuoles or patched structures are myeline sheath (M) after lipid component is extracted during preparation (Figs. 7-49 and 7-50). With continuation of an axon, the invagination between adjacent empty vacuoles is node of Ranvier (R). Those patched outlines and purple structures covering the axon are cytoplasm (C) of Schwann cells (S). Pink portions seen outside along with the myeline sheath are endoneurium (E).
In the other longitudinal section of nerve bundles stained by HE (Fig. 7-51), similar images can be seen as in the above one (Fig. 7-48). Nerve bundle (N) is encapsulated by epineurium (Ep) with adipose tissue (A) attached. Inside the nerve bundle, perineurium (Pe) separates it into two neve fasciculi (F). At high magnification (Figs. 7-52 and 7-53), nodes of Ranvier (arrow) are seen within intervals. Axons (A) can be identified when they are seen to be covered by pathed structures. Myeline sheath (M) are seen as vacuoles or pathed structures which have pick outlines representing cytoplasm of Schwann cells (S). Endoneurium (E) are seen as red bands outside the myeline sheath. Fibroblasts (F) can also be seen.
Silver impregnation is a stain technique used to visualize neurons, neurofibrils, and reticular fibers in tissue sections and make these structures black or brown. In a cross section of nerve bundle (Fig. 7-54) encapsulated by epineurium (Ep). There are six nerve fasciculi (F) inside the nerve bundle. Each fasciculus is encapsulated by perineurium (Pe). At high magnification (Figs. 7-55 and 7-56), inside each fasciculus encapsulated by perineurium (Pe), there are many crosscut tubular structures with “lifebelts” as tube walls. Most of these tubes are cut tangentially. They are myelinated fibers with a core of axon (A) wrapped by a lifebelt-like myeline sheath (M). Between myelinated fibers, it is filled with fibrous connective tissue invaginating from the perineurium (Pe) and surrounding each myelinated fiber to form endoneurium, which are stained dark brown or light brown.
In a longitudinal section of a nerve bundle encapsulated by epineurium (Ep), there are fasciculi (F) seen inside the nerve bundle (Fig. 7-57). Each fasciculus contains numerous myelinated nerves which are composed of axons (A) as core and myeline sheath (M) as wall (Fig. 7-58). In one myelinated fiber, node of Ranvier (R) is seen clearly with an axon (A) passing through. Myeline sheath (M) wrap around the axon. Above it ,the other myelinated fiber can be seen to be covered by cytoplasm of Schwann cell (SC). Beneath it, the central portion of another myelinated fiber is found to have mixed images of axon and cytoplasm of Schwann cell (AC). The other micrograph taken from the same section shows seven nerve fibers (Fig. 7-59). Five of them can be seen to have clear cored axons (N1, N3, N4, N6) or trace of axon (N7) surrounded by vacuole-like myelin sheaths (M). Two of them (N2, N5) show that the cutting is not through the cored axons. Only myelin sheaths (M) are found inside the sectioned “tubes”. Nodes of Ranvier (arrow) are seen on tow nerve fibers (N2, N5).
Myelin is mainly composed of lipid. Osmic acid is a selective stain for unsaturated lipids and for lipoproteins such as myelin which is stained black. In a micrograph taken from longitudinal section of nerve bundle (Fig. 7-60) encapsulated by epineurium (Ep), there are three nerve fasciculi (F) within respective perineurium (Pe). Adipose tissue (A) is found to be attached to these fibrous capsules. In one fasciculus nearby perineurium (Pe), one myelinated nerve is located and magnified (Fig. 7-61). It is found that this myelinated nerve is composed of light-stained axon (A) in the core wrapped by dark-stained myelin sheath (M). A node of Ranvier (R) is seen between two axonal segments without being wrapped by myelin sheath.
In cross section of a nerve bundle (Fig. 7-62), nerve fasciculi (F) are encapsulated by respective perineurium (Pe). Light-stained fibrous connective tissue is seen to contain adipose tissue (A). At high magnification (Fig. 7-63), each myelinated fiber has an axon (Ax) in as central core encircled by dark-stained myelin sheath (M).
Unmyelinated Nerve Fibers
As being stated above, while myelination is made by plasma membrane of one Schwann cell wrapping segment of one axon for several concentric layers, one or more axons could become longitudinally invaginated into Schwann cell, then this axon or these axons are unmyelinated or non-myelinated. To make a comparison between myelinated fiber and unmyelinated fiber, Both longitudinal sections of two kinds of fibers are stained by MS. In myelinated fiber (Fig. 7-64),the node of Ranvier (R) still looks like that seen in HE section (Figs. 7-49, 7-50). Blue-stained axon (A) is surrounded by patched structures which are parts of myelin sheath (M). Endoneurium (E) is stained blue instead of red seen in the HE stained section. Cells are not stained well here. In unmyelinated fiber (Fig. 7-65), the patched structure, i.e., myelin sheath, is not found. However, Schwann cells (S) are visible. Endoneurium (E) is stained blue with fibroblast (F).
Optic Nerve
Optic nerve is a part of the central nervous system. It is a good example to observe myelination in the CNS. In a cross section of mammalian optic nerve stained by HE (Fig. 7-66), the entire optic nerve is encapsulated by the epineurium (Ep). There are many nerve fasciculi (F) seen in the optic nerve. Each fasciculus is surrounded by perineurium (Pe). An empty space seen between epineurium (Ep) and nerve bundle is artificially separated during the preparation (Fig. 7-67). However, both nerve fasciculi (F) and perineurium (Pe) are intact. At the high magnification (Fig. 7-68), individual axons (A) are seen to be surrounded by myelin sheath which looks vacuoles due to loss of lipid in preparation. Oligodendrocytes (O), which are in charge of making myelin sheath, are found. Fibroblasts (F), which contribute to produce endoneurium, can also be found.
In a cross section of mammalian optic nerve stained by MS (Fig. 7-69), the entire nerve is encapsulated by epineurium (Ep) and contains nerve fasciculi (F) surrounded by perineurium (Pe). There is adipose tissue (A) with blood vessels attached to the epineurium. Inside each fasciculus (Figs. 7-70 and 7-71), there are many myelinated nerves. Each myelinated nerve is made of cored axon (A) and surrounding myelin sheath (M) followed by endoneurium (En). Both oligodendrocytes (O) and fibroblasts (F) can also be found.
Synaptic Contacts Between Neurons
As stated above, axons make synaptic contacts on other neuronal bodies or dendrites in the CNS and PNS ganglia. Although fine structure of a synapse cannot be observed at the light microscopic level, synaptic boutons or terminal boutons which are small swellings at the ends of axons representing sites of synapses can be seen under the light microscope after silver impregnation. A section of cat spinal cord is used to reveal the appearance of synaptic boutons (Fig. 7-72). There are numerous dark dots attached on the surface of cell bodies and dendrites of motor neurons (Figs. 7-73 and 7-74).
Synaptic Contacts From Neuron to Muscle
In the PNS, synaptic contacts may occur at neuromuscular junctions from nerves to muscles, or neuroglandular junctions from nerves to glands. Although detailed structure of the neuromuscular junction is unseen at light microscopic level, motor end plate, a specialized muscle membrane contacted by corresponding axon terminal, can be identified clearly under the light microscope. Different shapes of motor end plate can be observed from teased preparation of muscle fibers with nerve fibers, stained by GC, as shown in following micrographs taken:
During observation of motor end plates (ME) in a teased preparation of muscle fibers with nerve fibers, stained by GC (Fig. 7-82), two kinds of muscle fibers can be seen. One is wide and the other is narrow. The wide ones are extrafusal fibers (Ex) and the narrow ones are intrafusal fibers (In). The intrafusal fiber with a swollen portion is known as nuclear bag fiber (NB). The other intrafusal fiber does not have a swollen portion, but a portion filled with single row of nuclei, is a nuclear chain fiber (NC). Both intrafusal fibers and extrafusal fibers comprise the entire neuromuscular spindle or muscle spindle. In one micrograph (Fig. 7-83), there are two extrafusal fibers (Ex) and two intrafusal fibers (In) identified. One intrafusal fiber is nuclear bag fiber (NB) connected with an afferent fiber (AF). The other intrafusal has a motor end plate (ME) connected with an efferent fiber (EF). In the other micrograph (Fig. 7-84), two extrafusal fibers (Ex) and two intrafusal fibers (In) are also identified. One intrafusal fiber is nuclear bag fiber (NB) and the other intrafusal has a motor end plate (ME). Nerve fibers (NF) are seen around but no fiber connection with motor end plate or nuclear bag fiber can be clearly identified.
In a section of muscle tissue stained by HE, many muscle spindles (MS) are seen (Fig. 7-85). They are cut longitudinally or tangentially.
Each muscle spindle (Fig. 7-86) is enclosed by a connective capsule (C) which separates intrafusal fibers (In) from extrafusal fibers (Ex). One intrafusal fiber has multiple nucleus line in single row. It is a nuclear chain fiber (NC). In one muscle spindle enclosed by connective capsule, both nuclear bag fiber (NB) and nuclear chain fiber (NC) are seen (Fig. 7-87). Intrafusal fibers (In) are distinguishable from extrafusal fibers (Ex) by their locations.
Sensory Receptors
To precise motor function, nervous system needs to receive stimuli from both external and internal environments. The stimuli are detected by specialized cells including photoreceptors for light, mechanoreceptors for touch and pressure, thermoreceptors for temperature, and chemoreceptors for chemical changes.
Among sensory receptors, Meissner’s corpuscles are mechanoreceptors for touch. They are small, encapsulated receptors found in the dermis of the skin, particularly of the fingertips, soles of the feet, nipples, eyelids, lips, and genitalia. In a section of thick skin stained by HE (Fig. 7-88), three Meissner’s corpuscles (M1, M2, M3) are found in dermal papillae. The thick skin has a thick layer of cornified cells (C) with clear layers of epidermis (E) and dermis (D). At high magnification (Fig. 7-89), a connective tissue capsule (C) is found to envelop the corpuscle. The nuclei (N) within the corpuscle belong to Schwann cells, which are seen to be arranged horizontally. Nerve fiber (Nf) can also be seen to be arranged horizontally. The other corpuscle found in the dermal papillae shows the nerve fiber (Nf) entering the corpuscle and twinning within the corpuscle (Fig. 7-90)
In the same section of the thick skin (Fig. 7-91), a mechanoreceptor for pressure, Pacinian corpuscle (P) can be found in the layer of hypodermis (Hd), which is beneath the dermis (D). The Pacinian corpuscle looks like a sectional onion. In the hypodermis, many sweat glands (Sg) and adipose tissue (A) can also be found. Pacinian corpuscles can be in organs other than skin. In section of visceral fat (Fig. 7-92), three encapsulated Pacinian corpuscles (P1, P2, P3) are seen to be surrounded by adipose tissue (Ad) with artery (A) and vein (V). At high magnification of P1 (Fig. 7-93), it is found that the entire corpuscle is composed of concentric lamellae of Schwann cells (S) separated by interstitial space and collagenous fibers. Inside the core of the corpuscle, a myelinated nerve fiber (MN) is found to be surrounded by Schwann cells (S). It is made of an axon (A) wrapped in myelin sheath (M). The P3 corpuscle is sectioned tangentially (Fig.7-92). At high magnification (Fig. 7-94), it shows that a myelinated nerve is found to enter the corpuscle. It contains a cored axon (A) wrapped in myelin sheath (M), which is formed by Schwall cells (S).
In the skin along the junction between dermis and epidermis, another type of sensory receptors can be found, i.e., free nerve endings. They are formed from very fine afferent fibers. In section of skin stained by SI (Fig. 7-95), layers of the skin can be recognized, such as stratum corneum (C), epidermis (E), dermis (D), and hypodermis (Hd). Dermal papillae (P) can also be identified. In the dermal papillae (Fig. 7-96), there are fine fibers (arrow), stained light brown, projecting into epidermis. They are assumed to be nerve fibers with free endings.
There are also sensory receptors in eye for vision, in ear for hearing and equilibrium, in nose for the sense of smell, and in tongue for the sense of taste. Traditionally they are described as organs of special sense and will be discussed in Special Sense Organs later.
NOTE:
- Only those organelles visible under the light microscope are discussed here. It is suggested that to study all organelles visible under the electron microscope through your histology textbook and atlas.
- All photos used for discussion are taken from DSMH digital slides as follows:
H050010 Muscle Spindle, teased preparation, human, GC. (Figs. 7-82, 7-83, 7-84)
H050011 Muscle Spindle, sec., human, HE. (Figs. 7-85, 7-86, 7-87)
H050020 Motor Endplate, teased preparation, mammal, GC. (Figs. 7-75, 7-76, 7-77, 7-78, 7-79, 7-80, 7-81)
H050021 Free Ending of Sensory Nerve, sec. of human skin, SI. (Figs. 7-95, 7-96)
H050022 Synaptic Bouton, sec. of cat spinal cord, SI. (Figs. 7-72, 7-73, 7-74)
H050030 Nerve Bundle, ls. and cs., human, HE. (Figs. 7-46, 7-47, 7-48, 7-49, 7-50)
H050031 Nerve Bundle, cs., human, HE. (Figs. 7-44, 7-45)
H050032 Nerve Bundle, ls, human, HE. (Figs. 7-51, 7-52, 7-53)
H050033 Nerve Bundle, ls. and cs., human, SI. (Figs. 7-54, 7-55, 7-56, 7-57, 7-58, 7-59)
H050041 Nerve Bundle, ls. human, OA. (Figs. 7-60, 7-61)
H050042 Nerve Bundle, cs., human, OA. (Figs. 7-62, 7-63)
H050043 Optic Nerve, cs., mammal, HE (Figs. 7-66, 7-67, 7-68)
H050046 Myelinated Nerve, ls., mammal, MS. (Fig. 7-64)
H050047 Non-myelinated Nerve, ls., mammal, MS. (Fig. 7-65)
H050048 Optic Nerve, cs., mammal, MS. (Figs. 7-69, 7-70, 7-71)
H050060 Spinal Ganglion, ls., human, HE. (Figs. 7-15, 7-16, 7-17, 7-18, 7-19, 7-20, 7-21, 7-22)
H050070 Sympathetic Ganglion, ls., human, HE. (Figs. 7-23, 7-24, 7-25, 7-26, 7-27, 7-28, 7-29, 7-30, 7-31, 7-32, 7-33, 7-34, 7-35)
H050071 Sympathetic Ganglion, ls., human, SI. (Figs. 7-36, 7-37, 7-38, 7-39)
H050080 Spinal Cord, cs., human, HE. (Figs. 7-5 ~ 7-7)
H050100 Cerebral Cortex, section of gyrus, human, HE. (Figs. 7-5, 7-6, 7-7, 7-8, 7-9, 7-10)
H050150 Cerebellar Cortex, sec. of folia, human, HE. (Figs. 7-11, 7-12, 7-12, 7-14)
H050200 Meissner’s Corpuscle, sec., human, HE. (Figs. 7-88, 7-89, 7-90, 7-91)
H050210 Pacinian Corpuscle, sec., human, HE. (Figs. 7-92, 7-93, 7-94)
H050230 Motor Neurons, smear of mammal spinal cord, MB. (Figs. 7-1, 7-2, 7-3, 7-4)
H050240 Auerbach’s Plexus, sec. of intestine, human, HE. (Figs. 7-40, 7-41)
H090210 Jejunum, cs., human, HE. (Figs. 7-42, 7-43) - Staining methods and results:
CV = cresyl violet, as methylene blue to stain rough endoplasmic reticulum to show clumps of Nissl substance, or Nissl bodies.
GC = gold chloride, used to the motor end plates a distinct color, making them visible against the muscle fibers.
HE = hematoxylin and eosin, used to stain cell nuclei blue and cytoplasm pink or red. Hematoxylin may also stain ribosomes and rough endoplasmic reticulum blue.
MS = Mallory stain, or Mallory’s trichrome stain, used to differentiate between cellular and connective tissue components, with nuclei and muscle appearing red, collagen blue, and erythrocytes golden-yellow.
OA = osmic acid, used to stain lipid contained structures such as adipose tissue and myeline sheath.
SI = silver impregnation, used to visualize neurons, neurofibrils, and reticular fibers in tissue sections and make these structures black or brown.